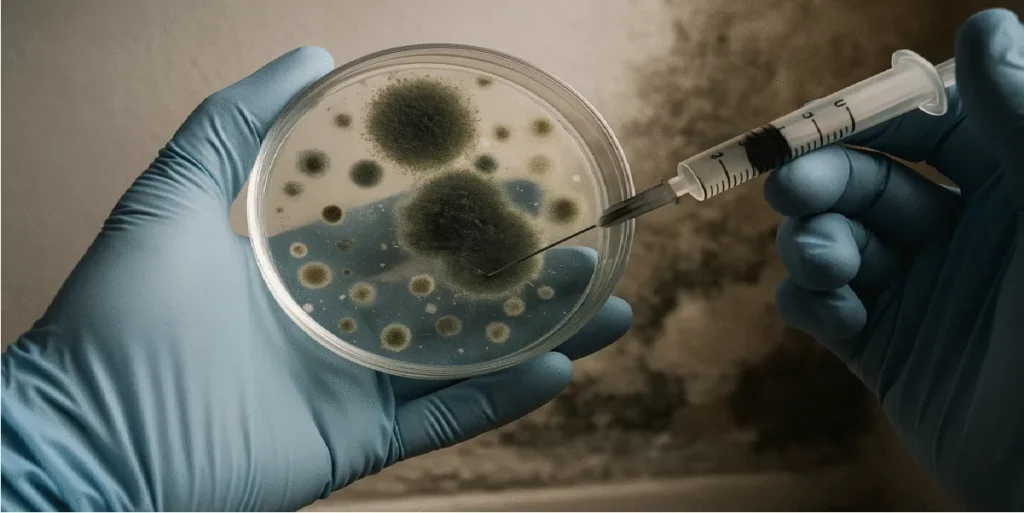
Extracción de muestra de moho en placa de Petri con jeringa, análisis en casa problemas de salud por humedad

Humedad y salud
Las humedades en casa no son solo un problema visual o estructural: son una amenaza silenciosa que impacta directamente en la salud de quienes habitan la vivienda. La conexión entre humedad en casa y salud es más directa de lo que parece. En España, miles de hogares lidian con problemas de humedad sin ser plenamente conscientes de sus consecuencias. Por ello, en este artículo te explicamos cómo detectar los diferentes tipos de humedad, cuáles son sus efectos en tu salud y qué soluciones tecnológicas te ofrece Humix para erradicarla de forma definitiva.
Te explicamos los tipos de problema y las soluciones que ofrecemos para combatir este problema. Despídete de las humedades con Humix.
¿Qué tipos de humedad existen y cómo afectan a tu hogar?
Entender los tipos de humedad en casa es clave para preservar la salud y evitar daños estructurales.

Antes de actuar, es fundamental conocer el origen de la humedad. Existen principalmente tres tipos, y cada uno requiere una solución específica:
1. Humedad por Capilaridad
Este tipo de humedad asciende desde el subsuelo a través de los cimientos y muros de la vivienda, provocando deterioro en la parte inferior de las paredes. Con frecuencia se observan eflorescencias salinas, desconchados en la pintura y una sensación de humedad constante en el ambiente. Además, es común en edificaciones antiguas sin barrera antihumedad.
2. Humedad por Condensación
Aparece cuando el vapor de agua generado por la actividad doméstica (como duchas, cocinas o incluso la respiración) entra en contacto con superficies frías, como cristales o paredes mal aisladas. Esto provoca la formación de moho negro, especialmente en esquinas, detrás de muebles o en techos. Es más frecuente en estancias mal ventiladas o con aislamiento deficiente.
3. Humedad por Filtración
Por otro lado, la humedad por filtración ocurre cuando el agua del exterior penetra en la vivienda a través de grietas, fisuras o defectos en la impermeabilización. Suele manifestarse en forma de manchas difusas que aumentan con la lluvia o el mal tiempo, especialmente en techos, sótanos o paredes exteriores.
Efectos de la humedad en casa sobre la salud
- Enfermedades respiratorias: asma, rinitis alérgica, bronquitis crónica.
- Problemas cutáneos: eccemas, urticaria, dermatitis.
- Dolores articulares y musculares: como artritis o fibromialgia, especialmente en personas mayores.
- Mayor vulnerabilidad: afecta con más severidad a niños, ancianos, embarazadas y personas con sistemas inmunológicos debilitados.
Estos problemas no son ajenos a muchos hogares en España, donde la humedad en casa y salud están íntimamente ligadas.

¿Qué dice la ciencia sobre la humedad en casa y salud?
Los estudios respaldan esta realidad:
- Los estudios respaldan una realidad alarmante: la humedad en casa y salud están estrechamente vinculadas. La Organización Mundial de la Salud señala que vivir en hogares con moho visible puede aumentar hasta un 40 % el riesgo de asma y hasta un 56 % el de alergias respiratorias OMS.
- Un estudio académico de la University of Exeter y otros centros sobre humedad interior encontró que altos niveles de humedad relativa —por encima del 70 – 80 %— aumentan significativamente las condiciones favorables para el crecimiento de moho en viviendas y pueden indicar un mayor riesgo para la salud respiratoria de los ocupantes. University of Exeter.
- Según un estudio citado en InfoSalus, vivir en hogares con humedad aumenta en un 50 % la probabilidad de que los niños sufran asma, tos e infecciones respiratorias, siendo la población infantil especialmente vulnerable.
- Por otro lado, investigaciones de la Universidad de Helsinki han demostrado que la exposición prolongada a ambientes húmedos y moho incrementa significativamente el riesgo de asma, bronquitis y sensibilización alérgica, confirmando la relación directa entre humedad y problemas respiratorios crónicos.
¿Síntomas de humedad en casa que afectan a la salud?
Evitar problemas de humedad en casa y salud comienza por un diagnóstico profesional. A veces los síntomas pasan desapercibidos. Por eso, es importante prestar atención a indicadores como:
Signos visibles:
- Manchas oscuras en paredes y techos
- Pintura descascarillada o papel pintado despegado
- Moho en esquinas o detrás de muebles
- Presencia de sales (eflorescencias) en las paredes
Sensaciones ambientales:
- Olor persistente a humedad
- Sensación de frío o pesadez en el aire
- Condensación en ventanas, incluso cerradas
Debes estar atento a señales como manchas de moho, pintura descascarillada o sensación de frío en el aire: todos son indicadores de que la humedad en casa y salud pueden estar siendo perjudicadas.

Detectar los primeros síntomas es esencial para evitar que la humedad en casa siga afectando la salud respiratoria y el bienestar diario.
Soluciones eficaces para combatir la humedad en casa y proteger tu salud
En Humix, combinamos innovación y experiencia para ofrecer tecnologías avanzadas, no invasivas y totalmente eficaces para combatir la humedad desde su raíz.
Sistema HS-221
Una solución revolucionaria frente a la humedad por capilaridad:
- Tecnología electromagnética sin obras ni mantenimiento
- Apto para viviendas de 100 a 2.500 m²
- Reducción de hasta un 80% de humedad en los primeros 3 meses
- Consumo eléctrico inferior a 10 € anuales
- Garantía de eliminación permanente de la humedad

Sistemas de Ventilación Inteligente
La mejor opción para combatir la condensación sin perder confort térmico:
- Renovación continua del aire interior con recuperación de calor
- Reducción del 90% de la humedad ambiental
- Sensores automáticos que regulan el funcionamiento según los niveles de humedad
- Mejora notable de la calidad del aire
- Eficacia en el 100% de los casos. Di adiós a la condensación

Detección avanzada con Cámara Termográfica
Identificamos con precisión los puntos de entrada de agua por filtración mediante termografía, para después actuar con las reparaciones adecuadas. De esta forma, evitamos intervenciones innecesarias y garantizamos un resultado duradero.

¿Por qué elegir HUMIX?
Porque no vendemos productos, ofrecemos soluciones completas. Nuestro compromiso va más allá de la tecnología: acompañamos a cada cliente desde el diagnóstico hasta la eliminación definitiva del problema, mejorando la calidad de vida de miles de familias en España.
En resumen, la relación entre humedad en casa y salud es directa, y suele concentrarse en tres riesgos significativos:
- Riesgo respiratorio y alérgico: la humedad favorece moho y ácaros, lo que puede agravar asma, rinitis, tos persistente e infecciones respiratorias, especialmente en niños y personas vulnerables.
- Riesgo de irritación y malestar físico: ambientes húmedos se asocian con dermatitis y eccemas, además de sensación de frío constante, dolor muscular o articular y menor bienestar diario.
- Riesgo de empeoramiento del problema: si no se actúa, la humedad tiende a cronificarse (capilaridad, condensación o filtración), aumentando la exposición y provocando daños en muros y acabados que hacen más difícil y costosa la solución.
Por eso, lo más importante es diagnosticar el origen y aplicar la solución adecuada: HS-221 para capilaridad, ventilación con control de humedad para condensación y reparación/impermeabilización guiada por diagnóstico para filtraciones. Si quieres, en Humix podemos ayudarte con un diagnóstico gratuito y un plan de actuación personalizado.
Las soluciones de Humix están diseñadas para protegerte de la humedad en casa y mejorar la salud de tu familia.
¿Quieres saber qué hacer para proteger tu hogar y tu familia? Consulta nuestras soluciones completas contra la humedad, conoce en detalle el funcionamiento del sistema HS‑221 de Humix para eliminar la humedad por capilaridad desde el origen y los equipos para controlar la humedad por condensación mediante ventilación descentralizada.
Si te preocupa la relación entre humedad en casa y salud, el equipo de Humix está preparado para ayudarte con soluciones reales.
Despídete de las humedades con Humix.
¡Actúa ahora y recupera un hogar saludable!
Toma el control hoy mismo y disfruta de un ambiente saludable en tu hogar.
Más información sobre nuestras técnicas de diagnóstico y tratamiento está disponible en humix.es/.
No esperes a que los efectos de la humedad empeoren.
Solicita ahora tu diagnóstico gratuito sin compromiso y empieza a respirar tranquilidad.
Preguntas frecuentes sobre humedad en casa y salud
¿La humedad en casa puede afectar realmente a la salud?
Sí. La relación entre humedad en casa y salud está ampliamente documentada. Vivir en ambientes húmedos favorece la aparición de moho y ácaros, lo que puede agravar problemas respiratorios, alergias y asma, especialmente en niños, personas mayores y personas con defensas bajas.
¿Qué enfermedades se asocian con la humedad en la vivienda?
Las más habituales son asma, rinitis alérgica, bronquitis crónica, infecciones respiratorias recurrentes y problemas cutáneos como dermatitis o eccemas. La exposición prolongada a humedad y moho también puede provocar fatiga, dolores articulares y malestar general.
¿Qué tipo de humedad es más peligrosa para la salud?
Todas pueden afectar, pero la humedad por condensación es especialmente problemática porque genera moho visible, cuyas esporas se inhalan fácilmente. La humedad por capilaridad y filtración también contribuyen a un ambiente insalubre al mantener los muros fríos y húmedos.
¿Cómo sé si la humedad de mi casa está afectando a mi salud?
Algunos indicios son la aparición frecuente de moho, olor persistente a humedad, condensación en ventanas y un aumento de síntomas respiratorios o alérgicos al pasar tiempo en casa. Si estos síntomas mejoran al salir de la vivienda, es una señal clara de alerta.
¿Ventilar abriendo ventanas es suficiente para eliminar la humedad?
No siempre. En muchas viviendas, abrir ventanas no es suficiente para controlar la condensación y puede incluso aumentar las pérdidas energéticas. Los sistemas de ventilación controlada con recuperación de calor permiten renovar el aire y reducir la humedad sin perder confort térmico.
¿Cómo ayuda el sistema HS-221 a mejorar la salud en casa?
El sistema HS-221 actúa sobre la humedad por capilaridad, deteniendo la ascensión de agua desde el terreno sin obras ni productos químicos. Al secar progresivamente los muros, se reduce el ambiente húmedo que favorece moho y problemas respiratorios.
¿Eliminar la humedad mejora también la calidad del aire interior?
Sí. Al reducir la humedad estructural y ambiental, disminuye la proliferación de moho y bacterias, mejora la sensación térmica y se consigue un aire interior más saludable, lo que tiene un impacto directo y positivo en el bienestar diario.
¿Qué es lo primero que debo hacer si sospecho que la humedad afecta a mi salud?
Lo más recomendable es realizar un diagnóstico profesional para identificar el tipo de humedad y su origen. En Humix analizamos cada caso y proponemos soluciones específicas para eliminar la humedad desde la raíz y proteger la salud de tu familia.